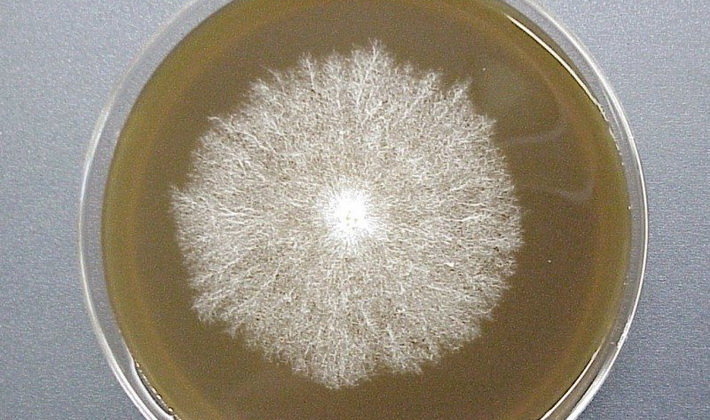

Façons de fabriquer soi-même du mycélium aux champignons
 Il existe de nombreuses façons d'obtenir du mycélium de champignons, et bon nombre d'entre eux ont été vérifiés dans les moindres détails au cours de nombreuses années d'expérience. Mais il existe également des méthodes de préparation du mycélium encore imparfaites et nécessitant des recherches supplémentaires. C’est ce que font les mycologues-praticiens du laboratoire et les cultivateurs de champignons amateurs qui cultivent du mycélium avec leurs propres mains à la maison.
Il existe de nombreuses façons d'obtenir du mycélium de champignons, et bon nombre d'entre eux ont été vérifiés dans les moindres détails au cours de nombreuses années d'expérience. Mais il existe également des méthodes de préparation du mycélium encore imparfaites et nécessitant des recherches supplémentaires. C’est ce que font les mycologues-praticiens du laboratoire et les cultivateurs de champignons amateurs qui cultivent du mycélium avec leurs propres mains à la maison.
Dans la nature, les champignons se propagent principalement par les spores, mais ce processus peut également être effectué à l'aide de morceaux de tissu de champignon, ce qui a longtemps été établi par les producteurs de champignons utilisant du mycélium sauvage comme matériel de plantation.
Comment fabriquer du mycélium à la maison est décrit en détail sur cette page.
Contenu
- Comment les gens cultivaient le mycélium
- Inconvénients de la croissance du mycélium de grain
- Comment obtenir de la gélose mycélium à la maison
- La première façon de préparer la gélose à la pomme de terre
- Comment faire de la gélose pour mycélium à la maison d'une autre manière
- Comment faire cuire le mycélium de champignon à la maison
Comment les gens cultivaient le mycélium
Auparavant, afin de cultiver certains types de champignons, par exemple les champignons, les gens cherchaient des tas de fumier et prenaient des ramasseurs de champignons à partir de là. Si le temps n'était pas favorable et qu'il n'y avait pas de mycélium dans les décharges, il était alors propagé dans des serres exploratoires spéciales. Pour ce faire, des sols de fumier (substrat) ont été préparés et le mycélium a été planté à cet endroit, sans le remplir de terre, afin d'éviter toute fructification. Après avoir attendu la germination presque complète du mycélium dans le substrat, les cultivateurs de champignons ont sorti le mycélium et l’ont utilisé comme matériel de plantation. Un tel milieu nutritif légèrement séché pourrait persister longtemps.
En Russie, le matériel de plantation de champignon avait été obtenu de la même manière dans les années trente. XIX siècle Cependant, lors de la croissance du mycélium en utilisant cette méthode, les rendements étaient médiocres, le mycélium a rapidement dégénéré et lors de la plantation, des microorganismes exotiques ont souvent été introduits, nuisant au développement normal du champignon et réduisant la fructification. Les scientifiques ont donc continué à rechercher de nouvelles méthodes de culture.
À la fin du XIXème siècle. en France, ils ont obtenu une culture de champignon stérile de champignon, cultivée dans un milieu nutritif spécial à partir de spores. Lors de la préparation du mycélium dans des conditions pures, le potentiel du mycélium a augmenté de manière significative;
Depuis le milieu des années 20. XX siècle Dans de nombreux pays producteurs de champignons, les laboratoires fonctionnaient, sachant non seulement préparer le mycélium, mais également parvenir à une excellente fructification. Dans les années 30 en URSS, en plus d'obtenir du mycélium sur du compost stérilisé, d'autres milieux nutritifs ont également été activement recherchés. En 1932, une méthode de culture du mycélium sur du grain de blé est brevetée. À l'heure actuelle, la plupart des producteurs de champignons du monde entier se consacrent à la culture du mycélium de grain.
Inconvénients de la croissance du mycélium de grain
Comme le montre la pratique, pour obtenir du mycélium, on utilise le plus souvent du mil, de l'orge, de l'avoine, du blé, du maïs, du seigle et d'autres céréales.Lors de l’élevage des pleurotes et d’autres cultures qui se développent dans la nature sur du bois, le mycélium est semé sur du grain, une balle de tournesol, du raisin pressé, de la sciure de bois, etc.
Selon le type de milieu nutritif sur lequel se développe le mycélium, ils distinguent le grain, le substrat, le mycélium liquide, etc.
Tous ces types de mycélium sont montrés sur la photo:




Le mycélium liquide n'est pratiquement pas répandu, le substrat substrat est utilisé un peu plus souvent, mais le grain est principalement utilisé. En raison du fait que le mycélium de grain dû aux éléments nutritifs du grain fournit une croissance accélérée du mycélium, il est utilisé dans la culture de champignons industriels.
Cependant, la préparation de ce mycélium dans des conditions industrielles ou domestiques a ses inconvénients. Tout d'abord, il s'agit d'exigences accrues pour la qualité de la stérilisation des grains. Si cette procédure n'aboutit pas, des moisissures apparaîtront qui gêneront le développement normal du mycélium, ce qui affectera nécessairement le volume de la récolte.
La courte durée de conservation du mycélium de grain (2-3 mois) est également un inconvénient important. De plus, il doit être conservé au réfrigérateur à une température de + 2-5 ° C, car cela inhibera le développement du mycélium. Si la température est plus élevée, cela entraînera une croissance continue du mycélium, à la suite de quoi il consommera rapidement des aliments et mourra.
Par l'apparition du mycélium, il est impossible d'établir le temps pour sa fabrication. Dans ce cas, la seule chose qui peut être recommandée est de faire preuve de vigilance lors de l’achat sur le côté, car les conditions de stockage ne sont peut-être pas remplies. Le mycélium étant de mauvaise qualité, le cultivateur débutant le découvrira plusieurs mois plus tard, lorsqu'il sera vain d'attendre la récolte.
Un autre inconvénient est le fait que le mycélium habitué au grain ne «voudra» pas se déplacer vers le bois.
Avec le mycélium de substrat, la situation est différente et son seul inconvénient est une croissance légèrement plus lente, mais il y a plus d'avantages: la stérilité, la possibilité de stocker à la température ambiante pendant un an.

Les cultivateurs de champignons amateurs préfèrent généralement le mycélium du substrat lors de la culture de champignons sur des segments en bois, car le taux de germination n'a pas d'importance. Ce processus se poursuit pendant plusieurs mois en raison de la forte densité de l'arbre.
Il est important de savoir que tout type de mycélium meurt s'il est chauffé à une température supérieure à 30 ° C.
Des organisations entières sont engagées dans la production de mycélium, dans lequel sont créées les conditions optimales pour sa culture. Certains attrapent du mycélium à la maison dans l’espoir de gagner un peu. Sa qualité ne satisfait pas toujours les exigences nécessaires, mais il convient de noter que, parfois, de très bons spécialistes se rencontrent également.
Bien sûr, les champignons peuvent se propager par les spores, mais la propagation à l'aide de mycélium est bien préférable pour un cultivateur débutant, car elle offre de meilleures chances de succès.
En outre, le processus d'obtention du mycélium est considéré en détail, car il est parfois simplement nécessaire de le cultiver soi-même, par exemple, si, pour une raison quelconque, le mycélium obtenu dans des conditions naturelles (par exemple, des morceaux de bois ou de terre pénétrés par le mycélium) ne suffit pas.
Les points clés pour la fabrication du mycélium de champignon avec vos propres mains sont les suivants. Tout d'abord, un fragment stérile du tissu fongique est retiré et transféré dans un milieu nutritif (ceci se produit en plusieurs étapes, qui seront discutées ci-dessous). Ensuite, plusieurs échantillons sont formés à partir de la culture principale, une attention particulière étant accordée aux mesures visant à prévenir l’infection de la culture. Ensuite, créez l’environnement et les conditions qui contribuent le plus à la fructification du champignon.
Au cours de ce processus, la culture subit les modifications suivantes: culture stérile sur milieu d'agar, culture stérile sur grain (mycelium de grain) et, enfin, fructification dans un milieu de culture pasteurisé.
Le mot "stérilité" peut effrayer certains débutants, mais il est absolument nécessaire de protéger la culture des champignons des nombreuses sources d’infection présentes partout dans l’environnement, quelle que soit la propreté de la pièce. Il est très important de les empêcher d'entrer dans la culture cultivée, car sinon, il y aura une «lutte» pour le milieu nutritif, et seule la culture de champignons devrait l'utiliser.
Avec une certaine précision et de la pratique dans l'exécution de techniques assez simples, toute personne peut effectuer le processus de stérilisation.
Ce qui suit décrit comment préparer la gélose pour le mycélium.
Comment obtenir de la gélose mycélium à la maison
Avant de préparer le mycélium à la maison, vous devez préparer un milieu de culture en gélose. L’agar à base d’algues marines et d’autres composants est souvent utilisé pour la culture primaire et l’isolement ultérieur de la culture des champignons.
Les experts ajoutent divers éléments nutritifs à la gélose, par exemple des minéraux, des antibiotiques, etc. L'intérêt du milieu gélosé réside également dans le fait que les micro-organismes qui causent l'infection peuvent être facilement détectés à la surface du milieu et qu'il est donc possible de les éliminer premiers stades de la culture.

Comme le montre la pratique, vous pouvez fabriquer le mycélium vous-même dans différents types de milieux d'agar. Le plus souvent, on utilise de la gélose à la pomme de terre et de la malt-dextrine. Ils peuvent être fabriqués indépendamment ou achetés en magasin. Mélanges prêts à l'emploi de la production industrielle.
En achetant de l'agar dans le magasin, vous devrez dépenser un peu plus cher, mais les dépenses supplémentaires sont compensées par la facilité d'utilisation, et en présence de finances et du manque de temps libre, les mélanges prêts à l'emploi seront le meilleur choix.

Si vous êtes habitué à le faire vous-même, alors, d’après les experts, l’agar à la pomme de terre pour mycélium de champignons à la maison peut être préparé de deux manières. Les deux méthodes diffèrent peu l'une de l'autre. De plus, après s’être familiarisé avec eux, chaque cultivateur de champignons peut très bien trouver sa propre voie.
Dans tous les cas, pour fabriquer correctement le mycélium de champignon, il est nécessaire de se préparer: des tasses à mesurer, un pansement en coton, du papier d'aluminium, un autocuiseur, des tubes avec capuchons à vis pour l'autoclavage (disponibles dans les magasins de matériel médical), un petit entonnoir pour le remplissage de tubes , 2 bouteilles d'un volume de 1 l, flacons à col étroit.
Ensuite, vous apprendrez comment préparer de la gélose à la pomme de terre pour le mycélium.
La première façon de préparer la gélose à la pomme de terre
Le rendement estimé de la substance est de 1 litre.
Ingrédients 300 g de pommes de terre, 20 g d’agar (il peut être trouvé dans les organisations fournissant du matériel pour les laboratoires médicaux, les magasins d’aliments santé ou les marchés asiatiques), 10 g de dextrose ou un autre sucre, 2 g de levure de bière (vous pouvez vous en passer). )
Processus de travail.
Étape 1 Avant de préparer de l'agar pour le mycélium grossier, vous devez faire bouillir les pommes de terre avec 1 litre d'eau pendant 1 heure, puis retirez-les en ne laissant qu'une décoction.
Étape 2 Mélangez bien le bouillon, l'agar, le sucre et la levure (si vous les utilisez), par exemple, avec un fouet pour fouetter, vous ne pouvez pas battre ce mélange.
Étape 3 Verser le mélange obtenu dans des bouteilles ou des flacons à la moitié ou aux trois quarts de leur volume.
Fermez les cous avec des cotons-tiges et enveloppez-les dans du papier aluminium. Versez de l'eau dans un autocuiseur de manière à ce que sa couche au fond de la vaisselle atteigne 150 mm et installez une grille sur laquelle placer les bouteilles ou les flacons. Placez le couvercle sur le plat et enclenchez les loquets.
Étape 4 Mettez le bain-marie sur le feu et attendez que la vapeur disparaisse. Après la ventilation, fermez la vanne pendant plusieurs minutes (selon le modèle et conformément aux instructions). Les bouteilles sont bouillies à 121 ° C (1 atm.) Pendant 15 minutes.Dans ce cas, il est nécessaire de veiller à ce que la température ne dépasse pas ce niveau, car dans ce cas, la caramélisation du milieu se produira, ce qui finira par le ruiner.
Étape 5 Au bout de 15 minutes, éteignez le feu et laissez la vaisselle refroidir (environ 45 minutes). Puis, sans perdre de temps, prenez des tubes libres, retirez les bouchons et placez les conteneurs sur un trépied ou dans des bidons propres, puis placez-les sur une surface préalablement nettoyée de la poussière et de la saleté.
Étape 6 Après avoir refroidi les bouteilles avec le milieu nutritif, retirez-les de l'autocuiseur avec une serviette ou des mitaines de cuisine. En mélangeant légèrement, retirez la feuille et les tampons, à l'aide d'un entonnoir, versez le contenu dans les tubes à essai d'environ un tiers.
Étape 7 Fermez les tubes avec les bouchons, mais moins fermement qu'auparavant, installez-les dans un autocuiseur, en versant l'excès d'eau, si nécessaire. Après avoir atteint une température de 121 ° C, laissez la vaisselle au feu pendant 30 minutes, puis laissez-la refroidir à nouveau lentement jusqu'à ce que la pression atteigne un niveau normal.
Étape 8 Sortez les tubes et vissez les bouchons. Verrouillez les tubes en position inclinée. En conséquence, la surface du milieu gélose doit être inclinée par rapport au ballon, afin de créer autant de surface que possible pour le développement ultérieur du mycélium (ces tubes sont parfois appelés «gélose oblique»).
Au fur et à mesure que le milieu refroidit, sa consistance devient de plus en plus semblable à une gelée et, finalement, durcit si bien que les tubes peuvent être placés verticalement et que le milieu en gélose reste dans la même position.
Cette vidéo détaille la préparation de la gélose au mycélium:
Les tubes à essai peuvent être utilisés immédiatement ou dans des semaines, voire des mois. Dans ce dernier cas, ils doivent être placés dans le réfrigérateur et, avant leur utilisation, assurez-vous qu'il n'y a aucune trace de moisissure ou d'infection bactérienne sur le support.
La prochaine section de l'article est consacrée à la manière d'obtenir une gélose à la pomme de terre pour le mycélium à la maison.
Comment faire de la gélose pour mycélium à la maison d'une autre manière
Le rendement estimé de la substance est de 1 litre.
Ingrédients
- 284 g de pommes de terre
- 21,3 g (3/4 oz) d'agar,
- 8 g de dextrose (le sucre de table peut être utilisé à la place)
Processus de travail.
Étape 1 Pour fabriquer l’agar au mycélium de vos propres mains, vous devez laver les pommes de terre et les couper en petits morceaux, en laissant les peaux, puis les faire bouillir dans 0,5 l d’eau jusqu’à cuisson complète. Enlevez les pommes de terre et leurs débris. Versez 1 litre d'eau dans du fer ou de la verrerie et ajoutez-y du dextrose (sucre), du bouillon et de l'agar-agar.
Étape 2 Dissoudre la gélose. Pour ce faire, placez le mélange de gélose obtenu dans un récipient recouvert de papier aluminium, dans un autocuiseur. Chauffer l'autocuiseur à 121 ° C (1 atm.) Et laisser. Après 20 minutes, la gélose se dissoudra complètement. Ensuite, éteignez le feu et laissez l’autocuiseur refroidir lentement.
Étape 3 À l'aide de gants de cuisine ou de serviettes dans des éprouvettes (ou de petites bouteilles), versez le mélange avec un tiers du volume avec de la gélose dissoute. Placez les tubes sur un trépied ou dans des canettes. Versez le reste de la gélose dans la bouteille, fermez-la avec un coton-tige ou un coton-tige et stérilisez-la plus tard, ainsi que les tubes restants.
Fermez bien les bouchons des éprouvettes ou des bouchons. Dans ce cas, la pression lors de la stérilisation sera égalisée. Si vous utilisez des tampons en coton ou en éponge, vous n'avez pas à vous soucier d'équilibrer la pression; toutefois, les tubes doivent également être recouverts d'une feuille d'aluminium, sinon la condensation de l'autocuiseur à refroidissement se formera sur les tubes.
Étape 4 Stérilisez la gélose pour laquelle les éprouvettes (bouteilles) sont installées dans un autocuiseur et maintenues à une température de 121 ° C (1 atm.) Pendant 25 minutes, sans compter le temps nécessaire pour atteindre la pression requise. Ensuite, éteignez le feu et laissez la vaisselle refroidir lentement.Vous ne devez pas permettre une diminution rapide de la pression. De ce fait, la gélose dans des tubes peut bouillir, éclabousser à travers des tampons et des bouchons de tube, ce qui pourrait entraîner une infection.
Étape 5 Au stade final, le mélange dans les tubes acquiert une position inclinée. Pour ce faire, essuyez la surface sur laquelle les tubes seront essuyés avec une solution à 10% d’agent de blanchiment contenant du chlore. Il ne devrait y avoir aucun courant d'air dans la pièce.
À l'aide de mitaines de cuisine ou d'une serviette de cuiseur à pression, retirez les tubes chauds et placez-les sur la table dans une position inclinée, en penchant le récipient d'un côté vers un objet. Avant cela, il est conseillé de choisir le bon angle d'inclinaison en utilisant des objets étrangers (barres, pile de magazines, etc.)
Lorsque la gélose commence à se solidifier, se transformant en gelée, fermez plus étroitement les bouchons (bouchons) dans les tubes.
L'agar de pomme de terre pour tube à essai est stocké dans un endroit frais et sans poussière.
Regardez la vidéo sur la fabrication de gélose pour mycélium de vos propres mains:
La dernière section de l'article est consacrée à la manière de bien cultiver le mycélium de champignons.
Comment faire cuire le mycélium de champignon à la maison
Avant de cultiver du mycélium à la maison, préparez: un scalpel (couteau tranchant à lame mince), une lampe à alcool (brûleur au propane avec une bombe aérosol, un briquet ou des allumettes), des bidons de fer ou des portoirs pour éprouvettes à gélose oblique et finis, un support pour scalpel ou un couteau, un pansement microporeux (un pansement standard peut être utilisé), un flacon pulvérisateur avec un mélange composé d’une partie d’eau de javel avec du chlore et de neuf parties d’eau (facultatif), un corps de fruit frais et propre du champignon (si vous êtes débutant, il est préférable de prendre des champignons pleurotes).
Processus de travail.
Étape 1 Avant de cultiver du mycélium, vous devez préparer une surface stable (table, comptoir), la laver à l’eau tiède savonneuse et l’essuyer. Pour assurer une désinfection supplémentaire, traiter la surface avec un aérosol avec une solution d'eau de Javel à 10%, essuyer soigneusement avec un chiffon propre ou une serviette en papier. Verrouillez les fenêtres en essayant d’exclure le plus possible la circulation d’air. Il est préférable de travailler le matin lorsqu'il y a peu de poussière dans l'air.
Étape 2 Pour développer le mycélium à la maison, vous devez organiser un espace de travail: disposez les outils et le matériel à portée de main, de manière pratique, prêts au travail.
Prenez des tubes d'agar et placez-les dans des boîtes de fer ou sur des supports. Allumez la lumière et stérilisez soigneusement la lame du couteau (scalpel), placez-la sur un support, par exemple, en fil métallique. Un support est nécessaire pour que la lame du couteau puisse toujours être près du feu lorsque l'outil n'est pas utilisé.
Étape 3 Prenez des champignons frais et propres. Bien que sa surface externe puisse contenir de nombreux agents pathogènes et moisissures, il n’ya généralement pas d’organismes dans les tissus internes susceptibles de provoquer une infection, bien sûr, s’il n’ya pas trop d’eau dans le champignon.
Pour casser une partie du champignon, il est impossible de la couper, car la lame infecte l'intérieur du champignon par des bactéries provenant de la surface externe. Placez le champignon sur la table avec une surface sale (propre ne doit pas être en contact avec la table).
La ligne du bas est que vous devez former une surface ouverte propre, et de lui prendre plus tard un petit morceau de tissu de champignon, qui est placé dans un tube à essai.
Étape 4 Afin de faire pousser le mycélium lui-même, disposez les outils et le matériel de manière à ce que le tube s’ouvre le moins possible avant de remplir le tissu fongique. Pour réduire le risque d'infection, le tube à essai (ou le bouchon, bouchon) ne doit pas être placé sur la surface de travail, ce qui est assez difficile. Il est donc judicieux de pré-entraîner avec un tube à essai vide.
Étape 5 La séquence suivante est dans une large mesure déterminée par le fait que le droitier ou le gaucher effectue ce travail. Les actions de ce dernier sont décrites ci-dessous.
Le pouce de la main gauche est abaissé, les autres sont horizontaux. Placez le tube entre le majeur et l'annulaire.Dans ce cas, l'annulaire est en haut, le majeur en bas de l'ampoule et le bouchon (bouchon) est dirigé loin de la main. Il n'est pas nécessaire d'incliner le tube, seule une position horizontale est requise ici, sinon les particules en suspension dans l'air auront plus de chances de pénétrer dans le goulot du conteneur. L'orientation du tube est telle que la surface biseautée de la gélose est dirigée vers le haut. C'est sur elle que seront plantés les tissus de champignons.
Étape 6 Retirez délicatement le bouchon (capuchon) du tube et prenez ce dernier de la manière indiquée.
À l'aide d'un index et d'un pouce libres de la main gauche, prenez un morceau de champignon dont la surface est propre. Avec votre main droite, prenez rapidement le scalpel comme s'il s'agissait d'un crayon ou d'un stylo. Déconnectez avec précaution un petit morceau de champignon triangulaire du tissu de champignon propre avec le bout de la lame et, sans attendre, placez-le dans un flacon sur le bord du cou en le secouant par des mouvements de tapotement, si nécessaire. Remettez le scalpel en place et fermez rapidement le tube avec un bouchon.
Étape 7 Tapotez légèrement la main avec un tube à essai de façon à ce qu'un morceau de champignon bouge sur la surface de la gélose. Placez le tube dans une autre boîte pour stocker les tubes inoculés.
Avec la mise en œuvre exacte des recommandations, il y a des chances considérables que la culture de champignons transplantée soit propre.
Une séquence similaire d’actions est réalisée avec d’autres flacons et du matériel de champignon. Il est important de préparer plusieurs éprouvettes à partir d'un seul champignon, car peu importe la qualité du travail, les infections se produisent souvent.
Une fois le matériel fongique introduit dans l’éprouvette (ce processus est appelé inoculation), le scalpel doit être à nouveau stérilisé au feu.
Une fois les tubes terminés, vous devez fermer le bouchon le plus étroitement possible et envelopper l'endroit avec du ruban microporeux, ce qui n'empêchera pas le champignon de «respirer» et empêchera en même temps les bactéries de pénétrer dans le tube par le cou.
Il est conseillé de placer des autocollants sur chaque ballon ou de faire des inscriptions avec un marqueur indiquant la date et des informations sur le contenu.
Les tubes prêts sont stockés dans un endroit sombre et frais à une température optimale de 13-21 ° C. Après un certain temps (plusieurs jours ou une semaine), le tissu du champignon se développera en peluche, ce qui indique le début du développement du mycélium. Après quelques semaines supplémentaires, le mycélium remplira toute la surface de la gélose.
En présence de moisissures, facilement reconnaissables par les spores de couleurs vertes ou noires, ou d'infection bactérienne (en général, cela ressemble à une substance glacée colorée), le contenu du tube doit être immédiatement jeté et lavé avec un bouchon dans de l'eau chaude savonneuse. Si possible, les tubes infectés sont débouchés dans une autre pièce où il n'y a pas de culture saine.
Des détails sur la culture du mycélium sont décrits dans cette vidéo:







